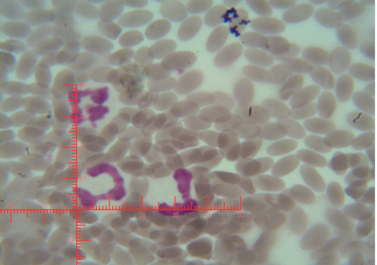
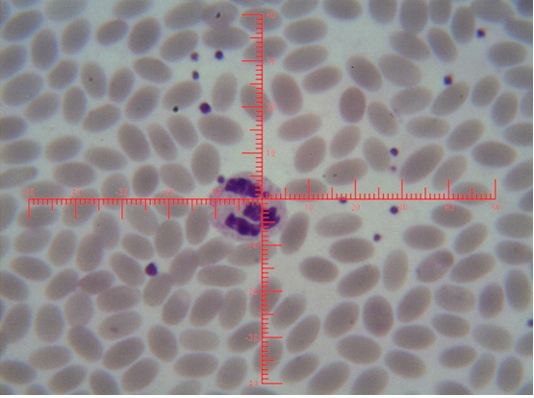

Advances in Animal and Veterinary Sciences
Shows sex chromatin types; small club, the horizontal and vertical dimension measurements in the nucleus of the neutrophils (x1000)
Shows sex chromatin type Sessile nodule, the horizontal and vertical dimension measurements in the nucleus of the neutrophils (x1000)
Shows sex chromatin type tears drop, the horizontal and vertical dimension measurements in the nucleus of the neutrophils (x1000)
Shows sex chromatin type tears drop, the horizontal and vertical dimension measurements in the nucleus of the neutrophils (x1000)
Shows the sex chromatin numbers and percentages of distribution sexual white blood cells (neutrophils) in local Iraqi camel.
Shows the sex chromatin characteristics and nucleus measurements in the local Iraqi she camels (mean ± SE).
Biochemical parameters and milk recipes studied in the local Iraqi market (general mean ± standard error)